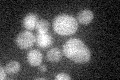
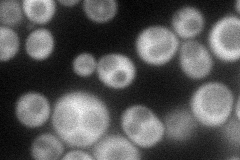
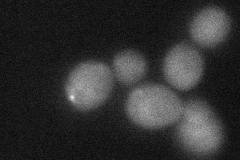

View description
Glc7-interacting protein whose overexpression relocalizes Glc7p from the nucleus and prevents chromosome segregation; may interact with ribosomes, based on co-purification experiments
Localization:
Intensity:
Fold change:
Significance:
-
C’ GFP library in SD
below threshold17 -
N' NOP1pr-GFP in SD
cytosol59.1338 -
N' TEF2pr-mCherry in SD

cytosol33.7732 -
N' NATIVEpr-GFP in SD

below threshold23.0628 -
N' TEF2pr-VC and Cyto-VN in SD
cytosol38.4769 -
C’ GFP library in SD+DTT

cytosol15.740.92No -
C’ GFP library in SD+H2O2

cytosol18.271.07No -
C’ GFP library in Starvation Media

cytosol15.560.91No -
C’ GFP library on the background of Pup2-DaMP

below threshold -
C’ GFP library on the background of CCT mutant

below threshold17.68141.03927No
